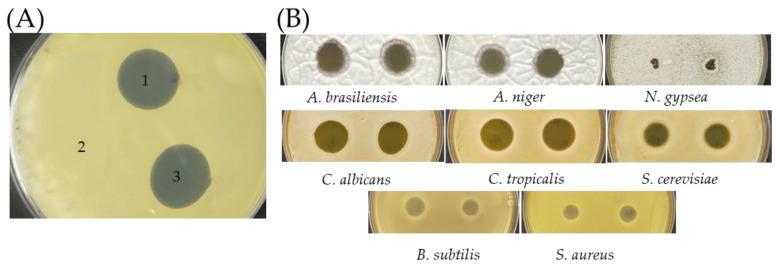
https://cdn.ncbi.nlm.nih.gov/pmc/blobs/8d68/9138071/31abfb3152d2/antibiotics-11-00679-g005.jpg

一种从土壤中分离出的物种产生了一种针对真菌和革兰氏阳性细菌的高分子量抗生素AF1。
A Soil-Isolated Species Produces a High-Molecular-Weight Antibiotic AF1 against Fungi and Gram-Positive Bacteria.
作者信息
Chang Pu-Chieh, Liu Shao-Chung, Ho Ming-Chun, Huang Tzu-Wen, Huang Chih-Hung
机构信息
Department of Chemical Engineering & Biotechnology, Institute of Chemical Engineering, National Taipei University of Technology, Taipei 10608, Taiwan.
School of Pharmacy, Taipei Medical University, Taipei 11031, Taiwan.
出版信息
Antibiotics (Basel). 2022 May 18;11(5):679. doi: 10.3390/antibiotics11050679.
The overuse of antibiotics has resulted in the emergence of antibiotic resistance, not only in bacteria but also in fungi. are known to produce numerous secondary metabolites including clinically useful antibiotics. In this study, we screened for antibiotic-producing actinobacteria from soils in Taipei and discovered a strain SC26 that displayed antimicrobial activities against Gram-positive bacteria and fungi, but the compounds are heat-labile. Upon UV mutagenesis, a late-sporulation mutant SC263 was isolated with the same antibiotic spectrum but increased in thermostability. The nature of the antibiotic is not clear, but its activity was resistant to proteolytic, nucleolytic and pancreatic digestions, and was retained by the 100 kDa membrane during filtration. To gather more information on SC263, the genome was sequenced, which produced three contigs with a total of 8.2 Mb and was assigned to the species of based on the average nucleotide identity to the reference species NBRC 15456.
抗生素的过度使用不仅导致了细菌,还导致了真菌产生抗生素耐药性。已知放线菌会产生许多次级代谢产物,包括临床上有用的抗生素。在本研究中,我们从台北的土壤中筛选产抗生素放线菌,发现了一株对革兰氏阳性菌和真菌具有抗菌活性的菌株SC26,但这些化合物对热不稳定。经紫外线诱变后,分离出一株产孢较晚的突变体SC263,其抗生素谱相同,但热稳定性提高。抗生素的性质尚不清楚,但其活性对蛋白水解、核酸水解和胰酶消化具有抗性,并且在过滤过程中被100 kDa的膜截留。为了获取更多关于SC263的信息,我们对其基因组进行了测序,得到了三个重叠群,总长8.2 Mb,并根据与参考物种NBRC 15456的平均核苷酸同一性将其归为该物种。